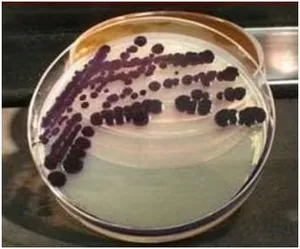

SUSTAINABLE DYEING INNOVATION

Ms. Ayman Satopay
People must be made aware of sustainable dyed fabric and garment in order for it to become widely accepted and as a result, demand and consumption will rise, infers Ayman Satopay.
The textile business is the world’s second-most polluting industry. Synthetic dyes are responsible for a significant portion of this pollution, with textile dyeing operations accounting for almost 20% of global water contamination. The use of non-biodegradable petroleum-based colourants to dye textiles, the use of toxic agents to fix colourants on textiles, and the release of huge amounts of these colourants and fixation agents into the surrounding ecosystem are the key contributors to this problem. After severe new rules were imposed a year ago, China shut down most of the enterprises creating synthetic textile dyes. Industries are now exploring towards greener ways to colour textiles as a result of those closures and severe environmental requirements.
Natural colours extracted from biodegradable plant sources may be a feasible alternative to synthetic colourants. Toxic fixing agents, on the other hand, must still be employed with these colourants. Across the board, the textile and apparel industries are looking for new ways to colour. Fabric has been dyed by humans for millennia. The earliest evidence dates from 3500 BC. All colours were manufactured using natural pigments and oils until 1856, when WH Perkins discovered the use of synthetic dyes. Synthetic dyes are now used in 90% of our clothing. We’ll look at contemporary difficulties in textile dyeing and treatment, as well as innovative technology and sustainable dying techniques, in this post. If you want to learn more about this scene, to check read our article on sustainable fashion startups [9].
Sustainability and its importance
The ability to remain and flourish in the future without depleting natural resources is referred to as sustainability. The United Nations defined sustainable development in the Brundtland Report as development that meets present demands without jeopardising future generations’ ability to fulfil their own. It is founded on the premise that resources are finite and should be used carefully and sparingly in order to ensure that future generations will have enough without decreasing current living standards. Environmental conservation and dynamic equilibrium in human and ecological systems must be prioritised by a socially responsible society [2].
We will not be able to maintain our Earth’s ecosystems or function as we do now unless we adopt more sustainable decisions. We will run out of fossil fuels, a substantial number of animal species will become extinct, and the atmosphere will be irrevocably affected if negative processes continue unchecked. Sustainability benefits include clean air and nontoxic atmospheric conditions, the increase of trustworthy resources, and the quality and cleanliness of water [2].
As individuals become more environmentally conscious as a result of the climate crisis, there is a contemporary push for sustainability to become a more desirable emphasis for businesses. Businesses will most likely be expected to have a positive climate impact across the entire value chain, enhanced influence on the environment, people, and atmosphere, and valuable contributions to society in the future. Companies will be held liable for all aspects of the sector, and any environmental damage or harmful emissions from manufacturing processes should be minimised or avoided [4].
Synthetic dyeing and problems associated with it Definition of dyes
Dyes are substances that are used to impart colour to textiles, paper, leather, and other materials in such a way that the colour is resistant to washing, heat, light, and other conditions that the material is likely to be exposed to. There are different types of dyes based on the source such as natural dyes which includes extracting dyes from natural resources such as vegetable, flowers, minerals etc. The other group of dyes is syn- thetic dyes which includes sulphur, vat and direct dyes which are manmade [1].
Pollution
Synthetic dyestuffs have negative effects on all kinds of life. Textile dyeing water is particularly toxic due to the presence of vat dyestuffs, nitrates, acetic acid, soaping chemicals, enzymatic substrates, chromium-based compounds, and heavy metals, as well as other dyeing additives. Formaldehyde-based colour fixing auxiliaries, chlorine-based stain removers, hydrocarbon-based softeners, and other non-biodegradable dyeing adjuvants are among the numerous hazardous chemicals utilised in dyeing. AZO dyes account for 60- 80% of all dyes, several of which are known to be car- cinogenic. Chlorobenzenes, which are often used to colour polyester, are harmful if inhaled or come into direct contact with the skin.
Local people and farmers living near rivers that have turned different colours have reported health issues and are concerned about the safety of the food they are required to raise in neighbouring fields, as well as the fact that all the fish have died and the lifeless river has turned to sludge. The dyeing process releases a variety of compounds into polluted water and chemicals, resulting in the death of aquatic life, soil degradation, and pollution of drinking water. The colouring process has a considerable environmental impact, and existing restrictions have been shown to be poorly enforced, such as in China, as seen by the Jian River disaster. An average t-shirt uses 16-20 litres of water during the dyeing process, implying that the worldwide textile sector discharges 40,000 – 50,000 tonnes of dyes into the water system on a yearly basis.
The absorption and reflection of sunlight entering the water is a major environmental concern with dyes. Light absorption reduces algae’s photosynthetic activity, which has a significant impact on the food chain because algae are at the bottom of the food chain, influencing all organisms above them. One of the main reasons that aquatic life suffers in regions where colours are released is a lack of algae, but another is the toxicity of the dyes themselves. One of the most important challenges today is a lack of clean drinking water, and as one of the most polluting industries, textiles – particularly textile dyeing – is responsible for many cases of pollution that renders fresh water unfit for use. In the worst-case scenarios, communities are forced to drink, wash clothes, bathe, and irrigate fields with filthy water, and the poisons they are exposed to can have disastrous consequences. Even when water treatment is in place, poisonous sludge is produced as a consequence of the process [1].
Consumption of water and energy
Another major issue related

Demand for change
New technologies are paving the way for more cost-effective, resource-efficient, and non-polluting sustainable dyeing options as more customers become aware of the negative impacts of present dyeing techniques. Pre-treatment of cotton, pressurised CO2 dye application, and, more recently, the synthesis of natural colours from microbes are all examples of dyeing technology innovation. Current dyeing technologies can assist minimise water use, replace inefficient processes with more efficient and cost-effective ones, and lessen the environmental impact [8].
Sustainable dyeing innovations
Hybrid pigments
Ecofoot is a university spin-off company that specialises in textile chemical solutions and has won numerous awards. It intends to address long-standing environmental and sustainability challenges in the textile dyeing business, such as reactive dyeing of cotton or polyester/cotton blends, and indigo dyeing. Ecofoot has created hybrid pigments that are made up of a dye chemically bonded to a polymer particle that reacts with cellulose fibres at temperatures as low as 25 degrees Celsius. This method does not necessitate the use of salt, which is normally required to push the dye into the fabric. This technology may be used to dye cotton items at low temperatures, as well as wool in a more environmentally friendly manner.
Ecofoot-Indigo, a hybrid pigment used in denim dyeing, avoids the use of harmful reduction chemicals, which are commonly used to convert indigo pigment to a water-soluble form. The sulfite and sulphate formed in the dyebath can cause a variety of difficulties when discharged into the wastewater, therefore common reducing agents are considered ecologically unfriendly. Auxiliaries were also developed by Ecofoot to prevent dye hydrolysis during the dyeing process, which usually necessitates severe washing-off techniques to remove the hydrolyzed colour. More than half of the water in the intermediate and final rinses can be conserved in the overall preparation and dyeing process when hybrid pigments and auxiliaries are used. H2COLOR forms a compound with the reactive dye, largely avoiding hydrolysis. There will be less hydrolysed dye to re- move throughout the washing-off process this way. It can save up to: 60% water, 40% time, 60% energy and 30% cost [7].

Powder dyes from textile fibres
Recycrom is a sustainable dye line created by Officinal, an Italian company, using recycled garments, fibre material, and textile scraps. It created a complex eight-step procedure (patent pending) in which all of the fabric fibres are crystallised into an incredibly fine powder that can be used as a pigment dye for fabrics and garments made of cotton, wool, silk, or any other natural fibre. Various processes, such as exhaustion dyeing, dipping, spraying, screen printing, and coating can be used to apply Recycrom to fabrics. Recycrom is applied as a suspension, whereas most dyes are administered as a chemical solution, allowing it to be easily filtered from water and thereby lowering environmental effect [2].
Cotton pretreatment

Cotton dyeing takes more water than other textiles. To make 1kg of cloth, around 200 litres of water are required. Dow created the ECOFAST Pure pre-treatment method, which is used before the dyeing pro- cess to create cationic cotton. Cotton that has been pretreated gains a persistent positive charge, allowing it to have a greater attraction for negatively charged compounds like dyes. This innovative process reduces the amount of dye and water used in cotton dyeing by 50%. There are 90% fewer process chemicals, [such as colours, salt, and other additions. Room temperature dyeing uses 40% less energy [4].

Natural or engineered micro-organisms
Colorifix uses bacteria to colour fabrics in a synthetic biological process that can save up to ten times the amount of water used. The lysis of the microorganisms is used to fix the dye-producing bacteria directly into the fabric using a carbon source solution, followed by deposition and fixation of the dye onto fabrics with a single heating cycle. This method does not necessitate the use of organic solvents in the dye extraction process, nor does it necessitate the use of fixing and reducing agents containing organic compounds. Denim dyes are being developed by University of California researchers utilising genetically modified E.coli bacteria to create indican, which can subsequently be converted to indigo via an enzymatic process. This innovative method for indigo dye solubilization eliminates the use of harsh chemical reduction agents in favour of an enzyme [2].
Innovative dyes and auxiliaries

In contrast to traditional reactive dyes, Huntsman Textile Effects created Avitera, a series of polyreactive dyes for cotton that rapidly link to fibre. Avitera dyes have a trifunctional chemical reactivity that allows for a high reaction and fixation rate with cellulosic fibre, with only a little amount of unfixed dye to be removed. This saves up to 50% on water and electricity, as well as using up to 20% less salt [6].
We are SpinDye
We are SpinDye dyes recyclable materials like post-consumer water bottles or discarded garments before they are spun into yarn. Colour pigments and recycled polyester are melted together without the need of water, resulting in a 75 per cent reduction in overall water usage. H&M recently announced that the dyeing technology developed by We are SpinDye® was used in their Conscious Exclusive collection [9].

Waterless Technologies for Sustainable Dyeing
Textile dyeing processes differ depending on the cloth type. Cotton dyeing takes longer and uses more water and heat because of the negative surface of the fibres. This means that cotton only absorbs around 75% of the colour used. To ensure colour retention, dyed cloth or yarn is washed and heated repeatedly, resulting in massive volumes of effluent [2].

- ColorZen
ColorZen pre-treats cotton before spinning it with a unique method. This pretreatment speeds up the dyeing process, saving 90 per cent of the water, 75 per cent of the energy, and 90 per cent of the chemicals that would normally be required for effective cotton dyeing [2].
Dispersed dyes are applied to a paper carrier in AirDye. AirDye transfers dye from the paper to the textile’s surface using just heat. The dye is coloured at a molecular level during this high-heat procedure. The paper used can be recycled, and the amount of water utilised is reduced by 90%. Also, because the fabrics do not need to be soaked in water and heat dried repeatedly, 85 per cent less energy is needed [2].
2.AirDye

Pigments from Microbes
Synthetic dyes are used to colour the majority of the clothing we wear today. The problem with them is that they require expensive raw materials such as crude oil, and the chemicals used are harmful to the environment and human health. Even while natural dyes are less hazardous than synthetic dyes, the plants that make up the dyes still require agricultural land and pesticides. Bacteria are being discovered in labs all over the world as a new technique to manufacture colour for our apparel. Streptomyces coelicolor is a microorganism that changes colour in response to the pH of the media in which it develops. It is possible to regulate what colour it develops by altering its environment.
To dye using bacteria, first autoclave the textile to avoid contamination, then pour a liquid medium containing bacterial nutrients over the cloth in a container. The wet material is then exposed to bacteria and kept for a few days in a climate-controlled chamber. The bacteria is “live dyeing” the cloth, which means that it is dyeing the textile as it grows. The material is cleaned and gently laundered to remove the bacterial medium’s odour before drying. Bacterial dyes utilise less water than traditional dyes and may be used to dye a wide variety of designs in a wide variety of colours [8].
Living Colour

It is a biodesign initiative headquartered in the Netherlands that is also looking into the possibility of colouring our garments with pigment-producing microorganisms. Living Colour and PUMA collaborated in 2020 to create the world’s first bacterially coloured sportswear collection [6].
Government initiatives for supporting sustainability in Textile industry
SURE Project
The Indian government is pursuing a number of measures and actions to help the textile industry grow. In the year 2020, the Ministry launched Project SU.RE. Sustainable Resolution. The Indian apparel sector has pledged to create a long-term route for the fashion industry. This project will help the industry meet the Sustainable Development Goals (SDGs) as well as long-term environmental, social, and corporate governance objectives. Its objectives include the following:
- Ensure universal access to water and sanitation, as well as long-term
- Ensure that everyone has access to energy that is affordable, reliable, sustainable, and
- Build a more resilient infrastructure, encourage inclusive and sustainable industrialization, and encourage
- Ensure sustainable consumption and production patterns through responsible consumption and production [5].
The Government has approved followings projects under the Research & Development scheme for improving sustainability of textile industries. (Rs. In Lakhs)
The Government has approved followings projects under the Research & Development scheme for improving sustainability of textile industries.
(Rs. In Lakhs)
S. No. | Project Name | Name of TRA/ Insti- tution | Sanctioned amount |
1 | Development of alternative eco friendly process for reduction clearing of dyed or printed polyester fabric using oxidation technique includ- ing advance oxida- tion. | MANTRA, Surat | 17.78 |
2 | Development of Eco-clothing by greener reduction process of natural indigo dye. | SITRA, Co- imbatore | 8.64 |
Govt Incentives to help MSMEs (Ministry of Micro, Small & Medium Enterprises)
The government has announced a Rs 3 lakh crore collateral-free automatic lending programme for enterprises, including MSMEs, as well as a Rs 20,000 crore subordinate debt programme for stressed MSMEs and a Rs 50,000 crore equity infusion through a fund of funds. The dye business relies on China for raw materials known as dye intermediates. The government’s latest package of incentives to help firms get through the Covid19 issue emphasizes industry self-sufficiency.
Conclusion
People must be made aware of sustainable dyed fabric and garment in order for it to become widely ac cepted. As a result, demand and consumption will rise. Workshops and symposia should be organized by large manufacturing houses, technical institutes, and research houses to propagate the benefits of natural dyes and new innovative dyeing techniques. Innovative dye innovations must undergo extensive research and development in order to increase their quality in terms of low cost and wider application.
Although these advancements are both promising and environmentally benign, there are still numerous obstacles to overcome. Because the textile industry is a high-pressure manufacturing industry, there is fierce rivalry for garment pricing. Manufacturers are finding it difficult to create finished garments in a sustainable manner without boosting prices beyond what consumers are prepared to pay due to rising raw-material costs. Working on these shortcomings will surely make a green difference in the textile Industry.
References Bibliography
- Hauser, J. (2011). Textile dyeing. InTech.
Webliography
- https://wtwi-global.com/technical-knowledge/ faqs/faq-what-is-sustainability
- https://www.intcom/chapters/70564
- https://www.prescouter.com/2018/11/sustainable-dyeing-innovations-greener-ways-colortextiles/
- https://pib.gov.in/PressReleasePage.aspx-?PRID=1811504
- https://cen.acs.org/business/consumer-products/new-textile-dyeing-methods-make/96/i29
- https://www.plugandplaytcom/resources/how-sustainable-dyeing-changing-textileindustry/
- https://textilevaluechain.in/news-insights/sustainable-dyeing-innovations-greener-ways-to-color-textiles/
- https://wfibre2fashion.com/industry-article/9161/sustainable-dyeing-technologies-in-thefashion-industry